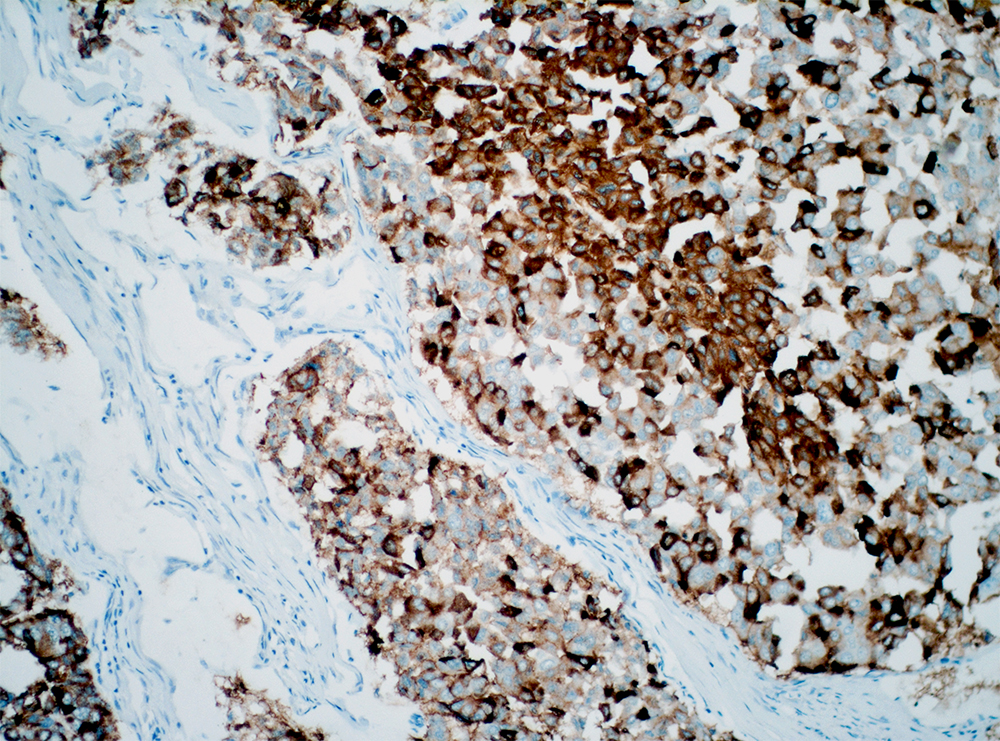
Anti-Mucin 1 (MUC1)

Anti-Mucin 1 (MUC1)
Mucins are high molecular weight glycosylated proteins, involved in the protection and lubrication of luminal epithelial surfaces. MUC1 is a ?transmembrane protein involved in several signaling pathways, including Ras, beta-catenin, p120 catenin, p53 and estrogen receptor alpha. Recent studies indicate MUC1 regulates gene expression, it enters the nucleus by complexing with beta-catenin and inside the nucleus it activates T-cell factor/leukocyte enhancing factor 1 transcription factors. ?MUC1 function as a signal transducer ?in various cancer progression, tumor invasion by inhibiting the cell-cell and cell-stroma interactions. Studies correlated MUC1 expression with invasive growth of ductal carcinomas (IDC) in the pancreas and cholangiocarcinomas in the liver and also with a non-invasive intraductal papillary mucinous tumors of the pancreas,. Additionally, MUC1 antibody aids in the prediction of the aggressiveness of carcinomas of the breast, stomach, colon, ampulla of Vater and renal cell carcinoma.?
| Intended Use | IVD |
|---|---|
| Antibody Type | Monoclonal |
| Clone | EP85 |
| Source | Rabbit |
| Tissue Type/Cancer Type | Breast |
| Pack | 0.5 mL – Manual – Concentrate, 1 mL – Manual – Concentrate, 6 mL – Manual – RTU, 50 Tests – Automation – Xmatrx, 100 Tests – Automation – i6000, 160 Tests – Automation – Xmatrx, 5 slides – Xmatrx, 5 slides – Manual, 50 tests – NanoVIP |